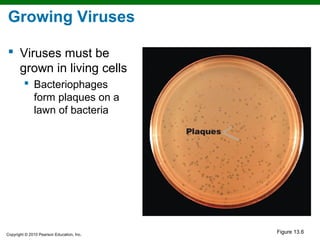
Growing Viruses

 Viruses must be
  grown in living cells
          Bacteriophages
           form plaques on a
           lawn of bacteria




Copyright © 2010 Pearson Education, Inc.
                                           Figure 13.6

Chapter 13 discusses viruses, viroids, and prions, emphasizing their structural characteristics and classification. It explains the life cycles of various viruses, including bacteriophages and animal viruses, as well as the relationships between certain viruses and cancer. Additionally, the chapter covers methods for growing, identifying, and understanding the implications of viral infections, including persistent and latent infections.